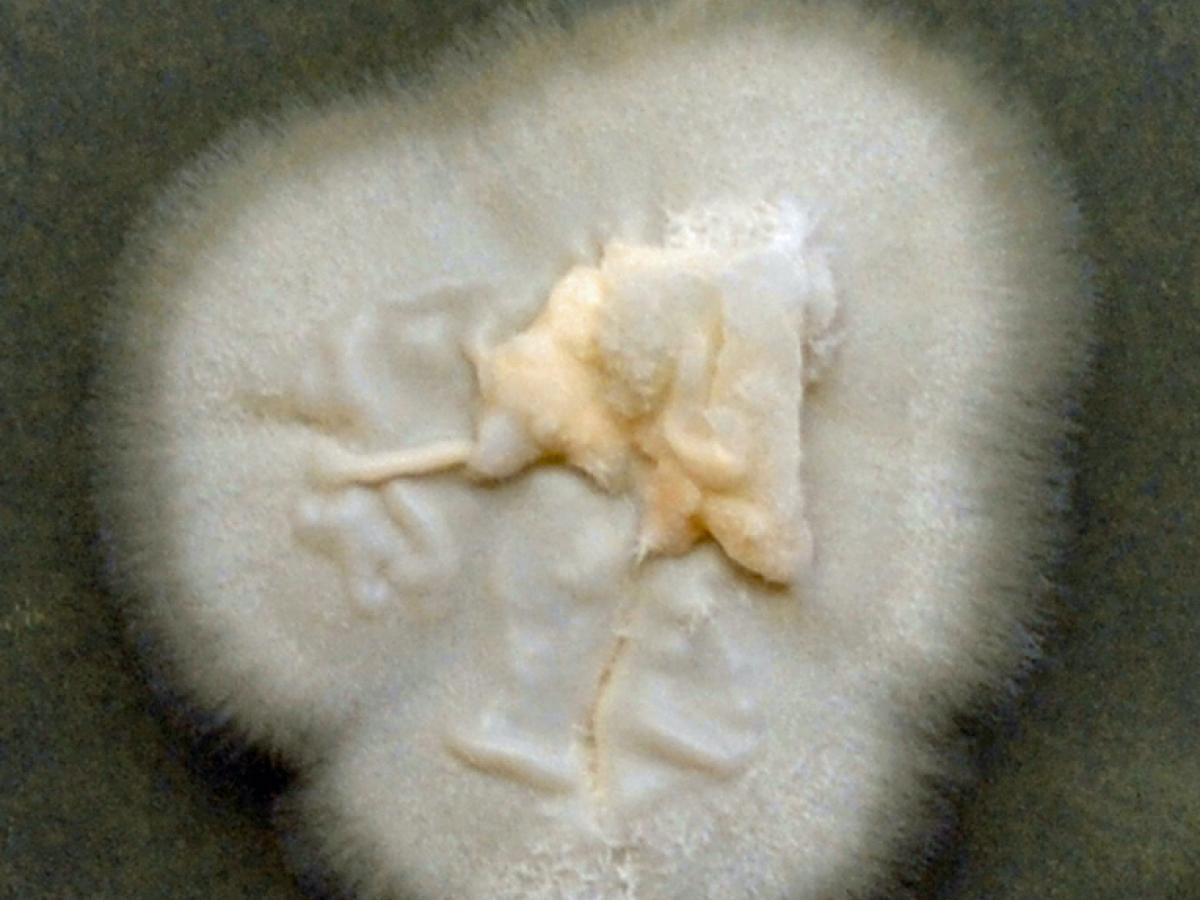
Sarocladium culture

Sarocladium
Based on a recent molecular phylogenetic study the taxonomy of Acremonium was reviewed and some medically important species have been transferred to Sarocladium; i.e. S. kiliense (formerly A. kiliense) and S. strictum (formerly A. strictum). Although these genera are morphologically similar they are phylogenetically distant.
Sarocladium can be morphologically differentiated from Acremonium by its elongated phialides rising solitary on vegetative hyphae or on conidiophores that are sparsely or repeatedly branched, the production of abundant adelophialides and elongated conidia. (Glenn et al. 1996, Summerbell et al. 2011, Giraldo et al. 2015).
Sarocladium strictum
Culture of Sarocladium strictum.
Sarocladium strictum is commonly found in soil and plant debris. Cutaneous, CAPD-related peritonitis and invasive infections in immunosuppressed patients have been reported.
RG-1 organism.
Morphological description:
Colonies growing rapidly, moist to slimy, pink or orange; reverse remaining colourless or turning pink to orange. Conidiophores simple, occasionally branched. Phialides slender, arising from submerged or slightly fasciculate aerial hyphae, 20-65 × 1.4-2.5 μm. Submerged sporulation frequent from reduced phialides. Conidia grouped in slimy heads, cylindrical or ellipsoidal, 3.3-5.5 × 0.9-1.8 μm, hyaline.

Sarocladium strictum showing slender phialides with conidia in slimy heads.
Molecular identification:
Summerbell et al. (2011) revised the genus and recommends using D1/D2 sequences for phylogenetic analysis and sequence-based identification.
| No | ≤0.016 | 0.03 | 0.06 | 0.125 | 0.25 | 0.5 | 1 | 2 | 4 | ≥8 | |
|---|---|---|---|---|---|---|---|---|---|---|---|
| AmB | 6 | 1 | 3 | 2 | |||||||
| VORI | 6 | 1 | 1 | 1 | 1 | 2 | |||||
| POSA | 6 | 1 | 1 | 2 | 1 | 1 | |||||
| ITRA | 6 | 1 | 1 | 1 |
References:
- de Hoog, G.S., Guarro, J., Gene, J., et al. (2015) Atlas of Clinical Fungi (Version 4.1.2). Centraalbureau voor Schimmelcultures, Utrecht, The Netherlands.
- Giraldo, A., Gene, J., Sutton, D.A., et al. (2015) Phylogeny of Sarocladium (Hypocreales). Persoonia, 34, 10-24.
- Glenn, A., Bacon, C.W., Price, R., et al. (1996) Molecular phylogeny of Acremonium and its taxonomic implications. Mycologia, 88, 369-383.
- Kidd, S., Halliday, C., Ellis, D. (2023) Descriptions of Medical Fungi (4th edition). CABI.
- Summerbell, R.C., Gueidan, C., Schroers, H.J., et al. (2011) Acremonium phylogenetic overview and revision of Gliomastix, Sarocladium, and Trichothecium. Studies in Mycology, 68, 139-162.
